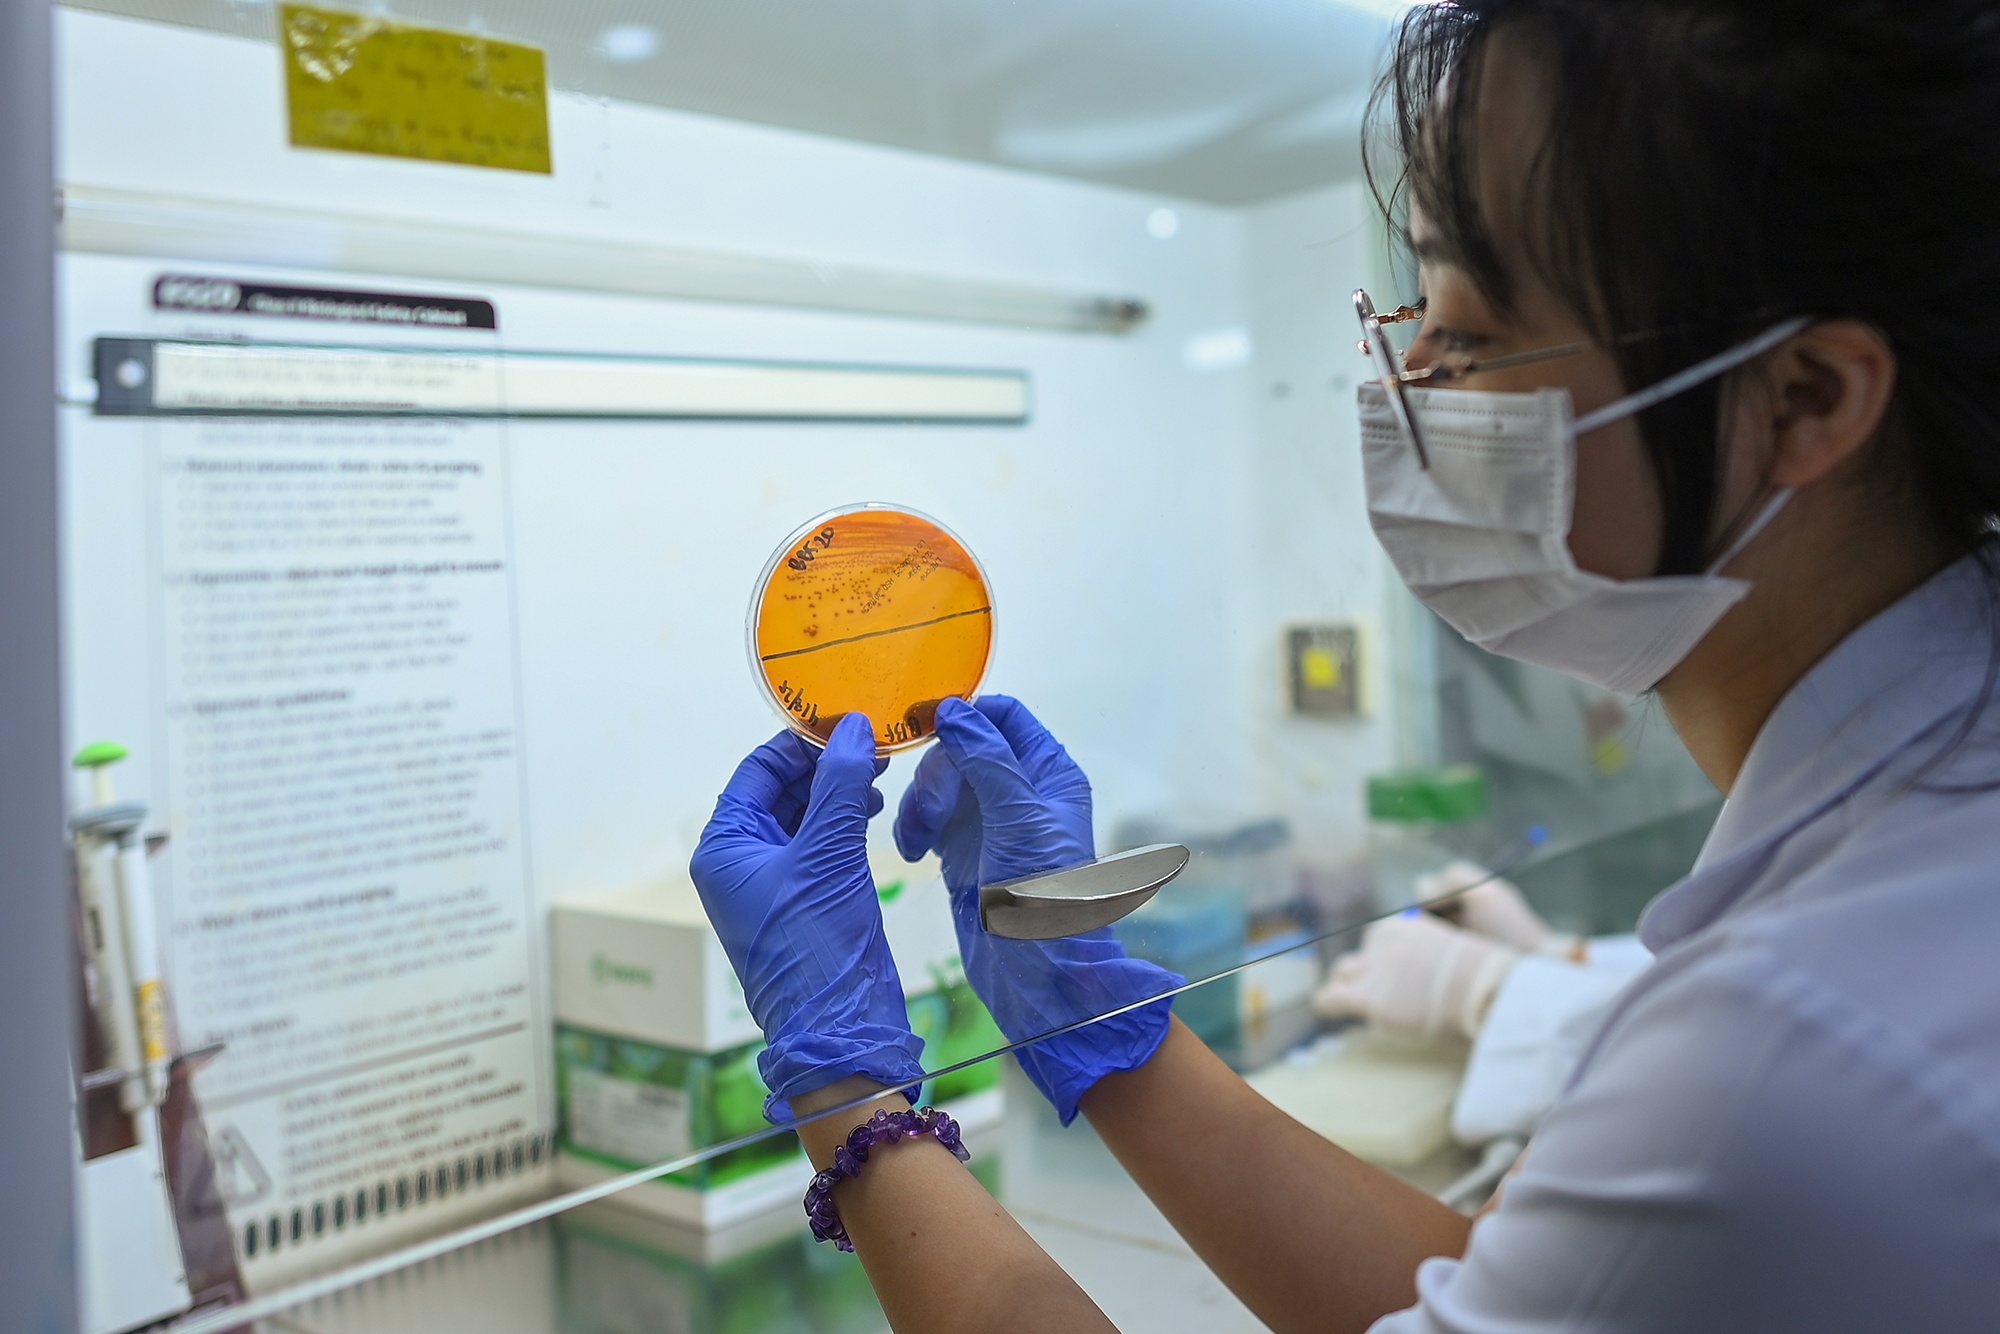
Khoa truyen nhiem vien 108 anh 26

'NGƯỜI GÁC CỬA' ĐẤU TRÍ TỪNG GIỜ VỚI BÓNG MA VIRUS VÀ VI KHUẨN
Nỗi sợ lớn nhất của bác sĩ truyền nhiễm không phải lây bệnh, mà là bị bỏ lại phía sau trong cuộc đua với virus và vi khuẩn biến đổi, nơi chỉ chậm một nhịp có thể mất mạng sống bệnh nhân.
“Phẫu thuật ngay!”
Giọng bác sĩ Thế dứt khoát, cắt phăng bầu không khí đặc quánh trong phòng hồi sức.
Chỉ trong tích tắc, ê-kíp lập tức vào guồng. Bệnh nhân lúc này thoi thóp trên lằn ranh sinh tử. Đó là một trong những dạng nhiễm trùng tàn khốc nhất: Nhiễm trùng "ăn mòn" từ lưng xuống chân, nội tạng gần như sụp đổ.
Ở khoa Hồi sức Truyền nhiễm, Bệnh viện Trung ương Quân đội 108, những tình huống như thế vẫn diễn ra hàng giờ. Đây là nơi tiếp nhận bệnh nặng nhất, những ca nhiễm trùng ngoài sức tưởng tượng được chuyển về từ khắp nơi, mỗi mét vuông đều sặc mùi thuốc sát trùng và sự tập trung tột độ.
 |
Đấu trí với "tử thần" trong ICU
"Điều trị ca bệnh này giống như bước đi trên băng mỏng", TS.BS Nguyễn Trọng Thế, Chủ nhiệm khoa Hồi sức Truyền nhiễm, Viện Lâm sàng các Bệnh truyền nhiễm, ví von về cuộc chiến tại phòng hồi sức cấp cứu (ICU). Ở nơi mà sự sống được tính bằng từng nhịp thở vay mượn từ máy móc, mỗi quyết định của bác sĩ đều là một cuộc cân não đầy nghiệt ngã.
Chỉ một sai sót nhỏ, một tính toán chệch nhịp, lớp băng mỏng ấy sẽ vỡ tan.
Hiện tại, ê-kíp dốc toàn lực để dựng lên những "hàng rào" bảo vệ cuối cùng cho bệnh nhân này: từ việc dùng kháng sinh phổ rộng đến hồi sức tuần hoàn, hỗ trợ gan thận. Thế nhưng, bài toán hóc búa nhất vẫn là ổ hoại tử đang chực chờ phát nổ.
    |
Với bác sĩ Thế, những ca nhiễm trùng nặng dù cam go cũng mới chỉ là "phần nổi". Điều thực sự khó nhất thường ẩn nấp sâu hơn ở tim hay thân não.
"Khi nhiễm trùng lan rộng gây biến chứng viêm cơ tim, chúng tôi phải tính đến hỗ trợ tuần hoàn bằng ECMO (hồi sức tim phổi nhân tạo). Còn với tổn thương não, có khi phải can thiệp mạch hoặc phẫu thuật mở sọ để giành giật sự sống", ông chia sẻ.
Nhưng khi đã đến giai đoạn này, y học không chỉ cần những kỹ thuật cấp cứu cao nhất, mà đôi khi còn cần cả bản lĩnh của người thầy thuốc khi đối đầu trực diện với tử thần để lội ngược dòng sinh tử.
 |
Toàn khoa hiện chỉ có 7 bác sĩ, trong đó chỉ 4 người đủ năng lực đảm nhiệm hồi sức chính. Sau mỗi ca trực kéo dài 36 tiếng là khối lượng công việc khổng lồ, từ giành giật sự sống tại giường bệnh đến áp lực giảng dạy và nghiên cứu khoa học.
 |
Nằm bất động trong căn phòng cách ly đặc biệt, ông N.H.N. (74 tuổi) đang phải đối mặt với những diễn tiến khốc liệt nhất của uốn ván giai đoạn khởi phát nặng. Ít ai ngờ rằng, một vết xước nhỏ ở cẳng tay trái lại thành "cánh cửa" nghiệt ngã cho vi khuẩn xâm nhập, đẩy người đàn ông ở tuổi thất thập vào một cuộc giằng co sinh tử không báo trước.
 |
Trong buổi điểm bệnh của Viện Lâm sàng các bệnh Truyền nhiễm, TS.BS Nguyễn Ngọc Quang, Phó Viện trưởng, lặng lẽ quan sát từng chỉ số sinh tồn của ông N. đang nhảy múa trên màn hình. Không khí đột ngột chùng xuống khi ông đặt ra bài toán hóc búa: "Làm sao để giảm trương lực cơ cho bệnh nhân?"
Giữa tiếng máy monitor bíp đều đặn, những nhận định chuyên môn và các luồng tranh luận của đội ngũ bác sĩ trẻ vang lên dồn dập.
Cuộc thảo luận không chỉ là chia sẻ chuyên môn mà là cuộc chạy đua với thời gian, mọi quyết định đều gắn liền với sự sống của người bệnh.
 |
Ở căn phòng kế bên, bà T.T.M. (76 tuổi) cũng đang trải qua những ngày tháng khắc nghiệt nhất của căn bệnh uốn ván. Bà phải nằm trong căn phòng bóng tối vì ánh sáng hay âm thanh mạnh đều có thể kích thích co giật.
 |
Hai thập kỷ, ông Đ.V.C. (57 tuổi) kiên trì sống chung với viêm gan B. Thế nhưng, chỉ một tháng tự ý ngừng thuốc, mọi nỗ lực đổ sông đổ bể. Cơ thể lập tức phản ứng bằng cơn suy gan cấp dữ dội. Gan tổn thương nghiêm trọng, ứ mật, xơ gan cổ chướng. Những độc tố bủa vây khiến sự sống của ông trở nên mong manh hơn bao giờ hết.
Bên giường bệnh, những túi huyết tương vàng óng đang lặng lẽ chảy vào huyết quản. Sau 3 lần thay huyết tương, chức năng gan có tín hiệu cải thiện.Tuy nhiên, BS Trương Ngọc Nam vẫn đầy ưu tư. Ranh giới giữa hồi phục và một cuộc đại phẫu xơ gan vẫn còn là một dấu hỏi lớn.
 |
Cuộc truy vết từng giọt máu
Vừa ngồi xuống bàn khám tại Viện Lâm sàng các Bệnh truyền nhiễm, ông Thiếp (62 tuổi) đã thều thào không ra hơi. Bốn ngày sốt cao liên tục cùng những cơn đau nhức toàn thân đã vắt kiệt sức lực của người đàn ông ngoại thành. Ngay lập tức, một loạt chỉ định từ xét nghiệm máu, siêu âm đến chụp X-quang phổi được phát ra để truy tìm căn nguyên đang tàn phá cơ thể ông.
Mỗi ngày, viện tiếp nhận từ 200 đến 300 ca cần lấy máu như thế.
 |
Xét nghiệm máu không chỉ là chỉ định thường quy mà đã thành nguyên tắc bất di dịch, một "chốt chặn" sinh tử để bóc tách những dấu hiệu nhiễm trùng ẩn náu sâu trong huyết quản.
Như Đại tá, TS.BS Vũ Viết Sáng, Viện trưởng Viện Lâm sàng các Bệnh truyền nhiễm, chia sẻ nơi đây không chỉ điều trị, mà còn là "người gác cửa" giữ nhịp bình yên trước những diễn biến khó lường của dịch bệnh.
 |
Những căn bệnh tưởng chừng đã lùi xa như sốt mò, liên cầu lợn, Whitmore hay uốn ván vẫn đang âm thầm quay lại. Chúng không ồn ào thành dịch, nhưng lại mang sức tàn phá âm thầm và quyết liệt.
"Có những bệnh diễn tiến nhanh đến mức nghiệt ngã. Bệnh nhân có thể rơi vào nguy kịch chỉ sau vài giờ", bác sĩ Sáng trăn trở. Giữa lằn ranh ấy, sự nhạy bén tại "cửa ngõ" này chính là cơ hội sống sót duy nhất của người bệnh.
    |
Để nhận diện chính xác những "kẻ thù vô hình" này, mọi mẫu bệnh phẩm đều được chuyển về Trung tâm Xét nghiệm, nơi các bác sĩ và kỹ thuật viên không ngừng truy tìm và xác định mầm bệnh.
 |
Nhờ hệ thống vận chuyển mẫu bằng khí nén và băng chuyền hiện đại, chỉ sau 1-2 phút, mẫu bệnh phẩm đã đến tay kỹ thuật viên. Tại phòng xét nghiệm, các máy móc tự động hoạt động liên tục: hệ thống miễn dịch xử lý tới 600 mẫu/giờ, còn máy sinh hóa thực hiện tới 3.600 xét nghiệm/giờ.
 |
Từ những dữ liệu thu được, bác sĩ có thể "đọc vị" chính xác loại vi khuẩn đang ẩn náu, đánh giá mức độ nhạy cảm hoặc kháng với từng loại kháng sinh, thậm chí phát hiện cả gene kháng thuốc.
    |
Tất cả được cô đọng trong tờ kết quả vẻn vẹn vài dòng, nhưng đằng sau đó là hàng giờ làm việc tỉ mỉ của đội ngũ kỹ thuật viên - mỗi con số không chỉ là dữ liệu khô khan, mà có thể là ranh giới sống - chết của một con người.
 |
Chạy đua với mầm bệnh
Nỗi lo lớn nhất của đại tá, tiến sĩ, bác sĩ Vũ Viết Sáng, Viện trưởng Viện Lâm sàng các Bệnh truyền nhiễm, và các bác sĩ không phải là nguy cơ bị lây nhiễm, mà là bị bỏ lại phía sau trong cuộc đua với mầm bệnh.
Virus và vi khuẩn luôn biến đổi, tìm cách vượt qua mọi hàng rào phòng thủ của con người. Trong mỗi trận dịch, chỉ cần chậm một nhịp, cái giá phải trả có thể là sinh mạng của người bệnh.
 |
| TS Vũ Viết Sáng, Viện trưởng Viện lâm sàng các bệnh truyền nhiễm - Bệnh viện Trung ương Quân đội 108) |
Để đáp trả thách thức, Viện tập trung vào ba mũi nhọn: Ứng dụng công nghệ gene để "giải mã" sớm các chủng kháng thuốc và dự báo dịch bệnh; Tối ưu hóa các kỹ thuật hồi sức đỉnh cao như ECMO, lọc máu để giành giật sự sống từ tay tử thần; Và cuối cùng, xây dựng bản đồ kháng sinh đồ để phá vỡ thế bế tắc trước các siêu vi khuẩn hiện nay.
|
Các bác sĩ Viện thường xuyên phối hợp với Trung tâm Nghiên cứu Y học Việt - Đức (VG-CARE), triển khai nghiên cứu cơ bản và ứng dụng lâm sàng. Trong mỗi dự án, bác sĩ phụ trách thu thập mẫu bệnh phẩm và đánh giá tình trạng lâm sàng, trong khi kỹ thuật viên nghiên cứu các kỹ thuật cận lâm sàng tiên tiến về sinh học phân tử và di truyền vi sinh vật.
 |
Phía sau những cánh cửa phòng lab, một cuộc hiệp đồng không tiếng súng vẫn diễn ra suốt ngày đêm. Từ soi - nhuộm, nuôi cấy đến giải trình tự gene và xét nghiệm miễn dịch, tất cả quyện hòa thành một mạng lưới truy tìm mầm bệnh chuẩn xác.
Mỗi mẫu bệnh phẩm không chỉ là con số. Đó là một cuộc chiến của tri thức, nơi y học hiện đại được đẩy đến giới hạn cao nhất để mang lại cơ hội sống thứ hai cho những người đang cận kề cửa tử.




